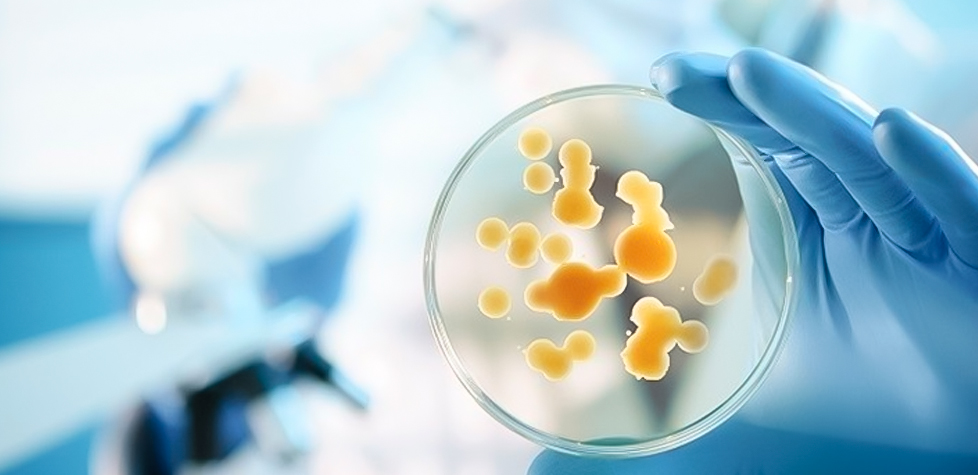

A enumeração microbiana da população de microrganismos em um produto para saúde
Redação
Um produto estéril para saúde é aquele livre de microrganismos viáveis. As normas técnicas, que especificam os requisitos para a validação e o controle de rotina de um processo de esterilização, requerem, quando for necessário fornecer um produto estéril para saúde, que as contaminações microbiológicas acidentais de um produto para saúde antes da esterilização sejam minimizadas. Tais produtos são não estéreis. O propósito da esterilização é inativar os contaminantes microbiológicos e, desse modo, transformar produtos não estéreis em estéreis. A cinética da inativação de uma cultura pura de microrganismos por agentes físicos e/ou químicos usados para esterilizar produtos para saúde pode, geralmente, ser melhor descrita por uma relação exponencial entre os números de microrganismos sobreviventes e a extensão do tratamento com o agente esterilizante. Inevitavelmente, isto significa que há sempre uma probabilidade finita de que um microrganismo possa sobreviver independentemente da extensão do tratamento aplicado. Para um dado tratamento, a probabilidade de sobrevivência é determinada pelo número e pela resistência dos microrganismos e pelo ambiente no qual os microrganismos existem durante o tratamento. Há requisitos e orientações normativos para a enumeração e a caracterização microbiana da população de microrganismos viáveis sobre ou dentro de um produto para saúde, em um componente, uma matéria-prima ou uma embalagem.
Da Redação –
A bioburden é a soma das contribuições microbianas de várias fontes, incluindo matérias primas, fabricação de componentes, processos de montagem, ambiente de fabricação, auxiliares de montagem/manufatura (por exemplo, gases comprimidos, água, lubrificantes), processos de limpeza e embalagem de produtos acabados. Para controlar a bioburden, deve-se dar atenção à categoria microbiológica dessas fontes. Existem métodos de determinação e caracterização microbiana da bioburden.
Para a determinação da bioburden e fazer a seleção de um método apropriado, o método deve ser apropriado para o objetivo para os quais os dados serão usados. O (s) método (s) deve (m) incluir técnicas para o seguinte: a neutralização de substâncias inibitórias, se necessário; a remoção de microrganismos, se apropriado; a cultura de microrganismos; e a enumeração de microrganismos.
Para a neutralização de substâncias inibitórias, se a natureza física ou química do produto for tal que possam ser liberadas substâncias que afetem adversamente a detecção de bioburden do produto, um sistema deve ser usado para neutralizar, remover ou, se ...



















